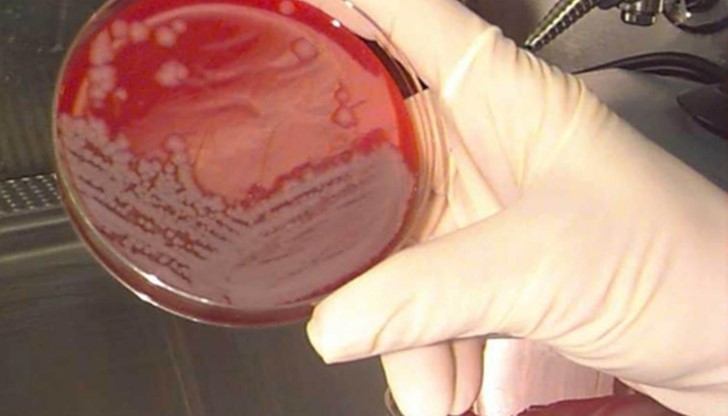
Уведомени са Регионалната здравна инспекция и Министерството на здравеопазването

Починал от антракс във Варна?
- Редактор: Иван Матев
- Коментари: 0
Съмнения за починал мъж от антракс има във Варна, съобщи Varnautre.bg. Уведомени са Регионалната здравна инспекция и Министерството на здравеопазването, но все още не е потвърдено, че пациентът е починал именно от това. Изчакват се резултатите.
"Спазили сме протокола, уведомени са всички, които трябва да се уведомят, но изчакваме резултатите и докато те не излязат, не можем да твърдим, че има случай на антракс. Може да се окаже, че е нещо съвсем различно", каза шефът на борда на директорите в "Св. Марина" проф. Красимир Иванов. Той подчерта, че към този момент място за паника няма. Проф. Иванов, допълни, че повече информация ще има веднага щом излязат резултатите от пробите.
Починалият пациент е мъж от село в областта. Преди да бъде приет в "Св. Марина", той е минал през няколко лечебни заведения. Последната преди Терапията е била варненската "Св. Анна". Той е бил приет в Спешното там, след което е откаран в "Св. Марина". В Окръжна болница също са спазили протокола по обеззаразяване и профилактика, който е утвърден при съмнение за антракс.
Директорът на Регионалната здравна инспекция във Варна д-р Дочка Михайлов уточни че, пробите от починалия във Варна пациент пътуват към София и всеки момент трябва да пристигнат в Националния център по вирусология и паразитология, където ще бъдат изследвани.
"Подчертавам, че става дума само за съмнение, но въпреки това сме спазили протокола такъв, какъвто е при наличие на антракс", обясни д-р Михайлова. "Издирваме пътя на пациента и всички хора, с които е бил в контакт, в това число и медицинския персонал от здравните заведения, където е пребивавал. Всички от тях вече са открити. Не мога кажа колко е точната бройка на хората, с които е бил в контакт, тъй като екипите още не са се върнали. На всички, за които е установено, че са били в контакт е направена крайна дезинфекция с хлорни препарати. Прави им се и профилактика с антибиотици", каза още шефката на РЗИ. "Много се надяваме, че става дума само за съмнение. В момента, в който получим резултатите, веднага ще ги обявим", завърши тя.
Антракс, по-известен у нас като синя пъпка, е остро заразно заболяване, което се характеризира с тежка интоксикация. Болестта се разпространява главно от трупове на заразени и умрели домашни и диви животни. По хората се разпространява чрез контакт със заразени животни, заразена почва, месо и предмети, имали досег с трупа. За лечение обикновено се предписват антибиотици. Лечението трябва да започне в началния стадий на болестта. Ако не се лекува, антраксът завършва със смърт.
























Младежите обявиха война на модела "Борисов – Пеевски"
Приятел на прегазеното от влак момче се опитал да го спаси в...
Пенсионери: С бонуса от 120 лева ще си купим разфасовано...
Пенсионери: С бонуса от 120 лева ще си купим разфасовано...
Пенсионери: С бонуса от 120 лева ще си купим разфасовано...